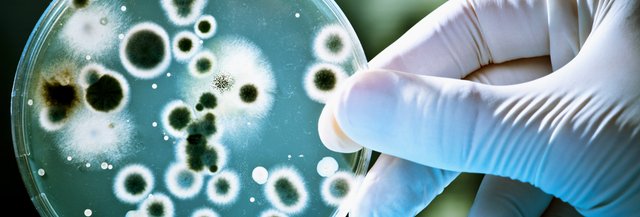
featured

tamagotchi reblogged
Emkaye (36)
122 followers29 posts15 following0 HP
Blacklisted UsersMuted UsersFollowed BlacklistsFollowed Muted Lists
Blacklisted UsersMuted UsersFollowed BlacklistsFollowed Muted Lists
lucena Joined June 2017 Active 6 years ago




.jpg)